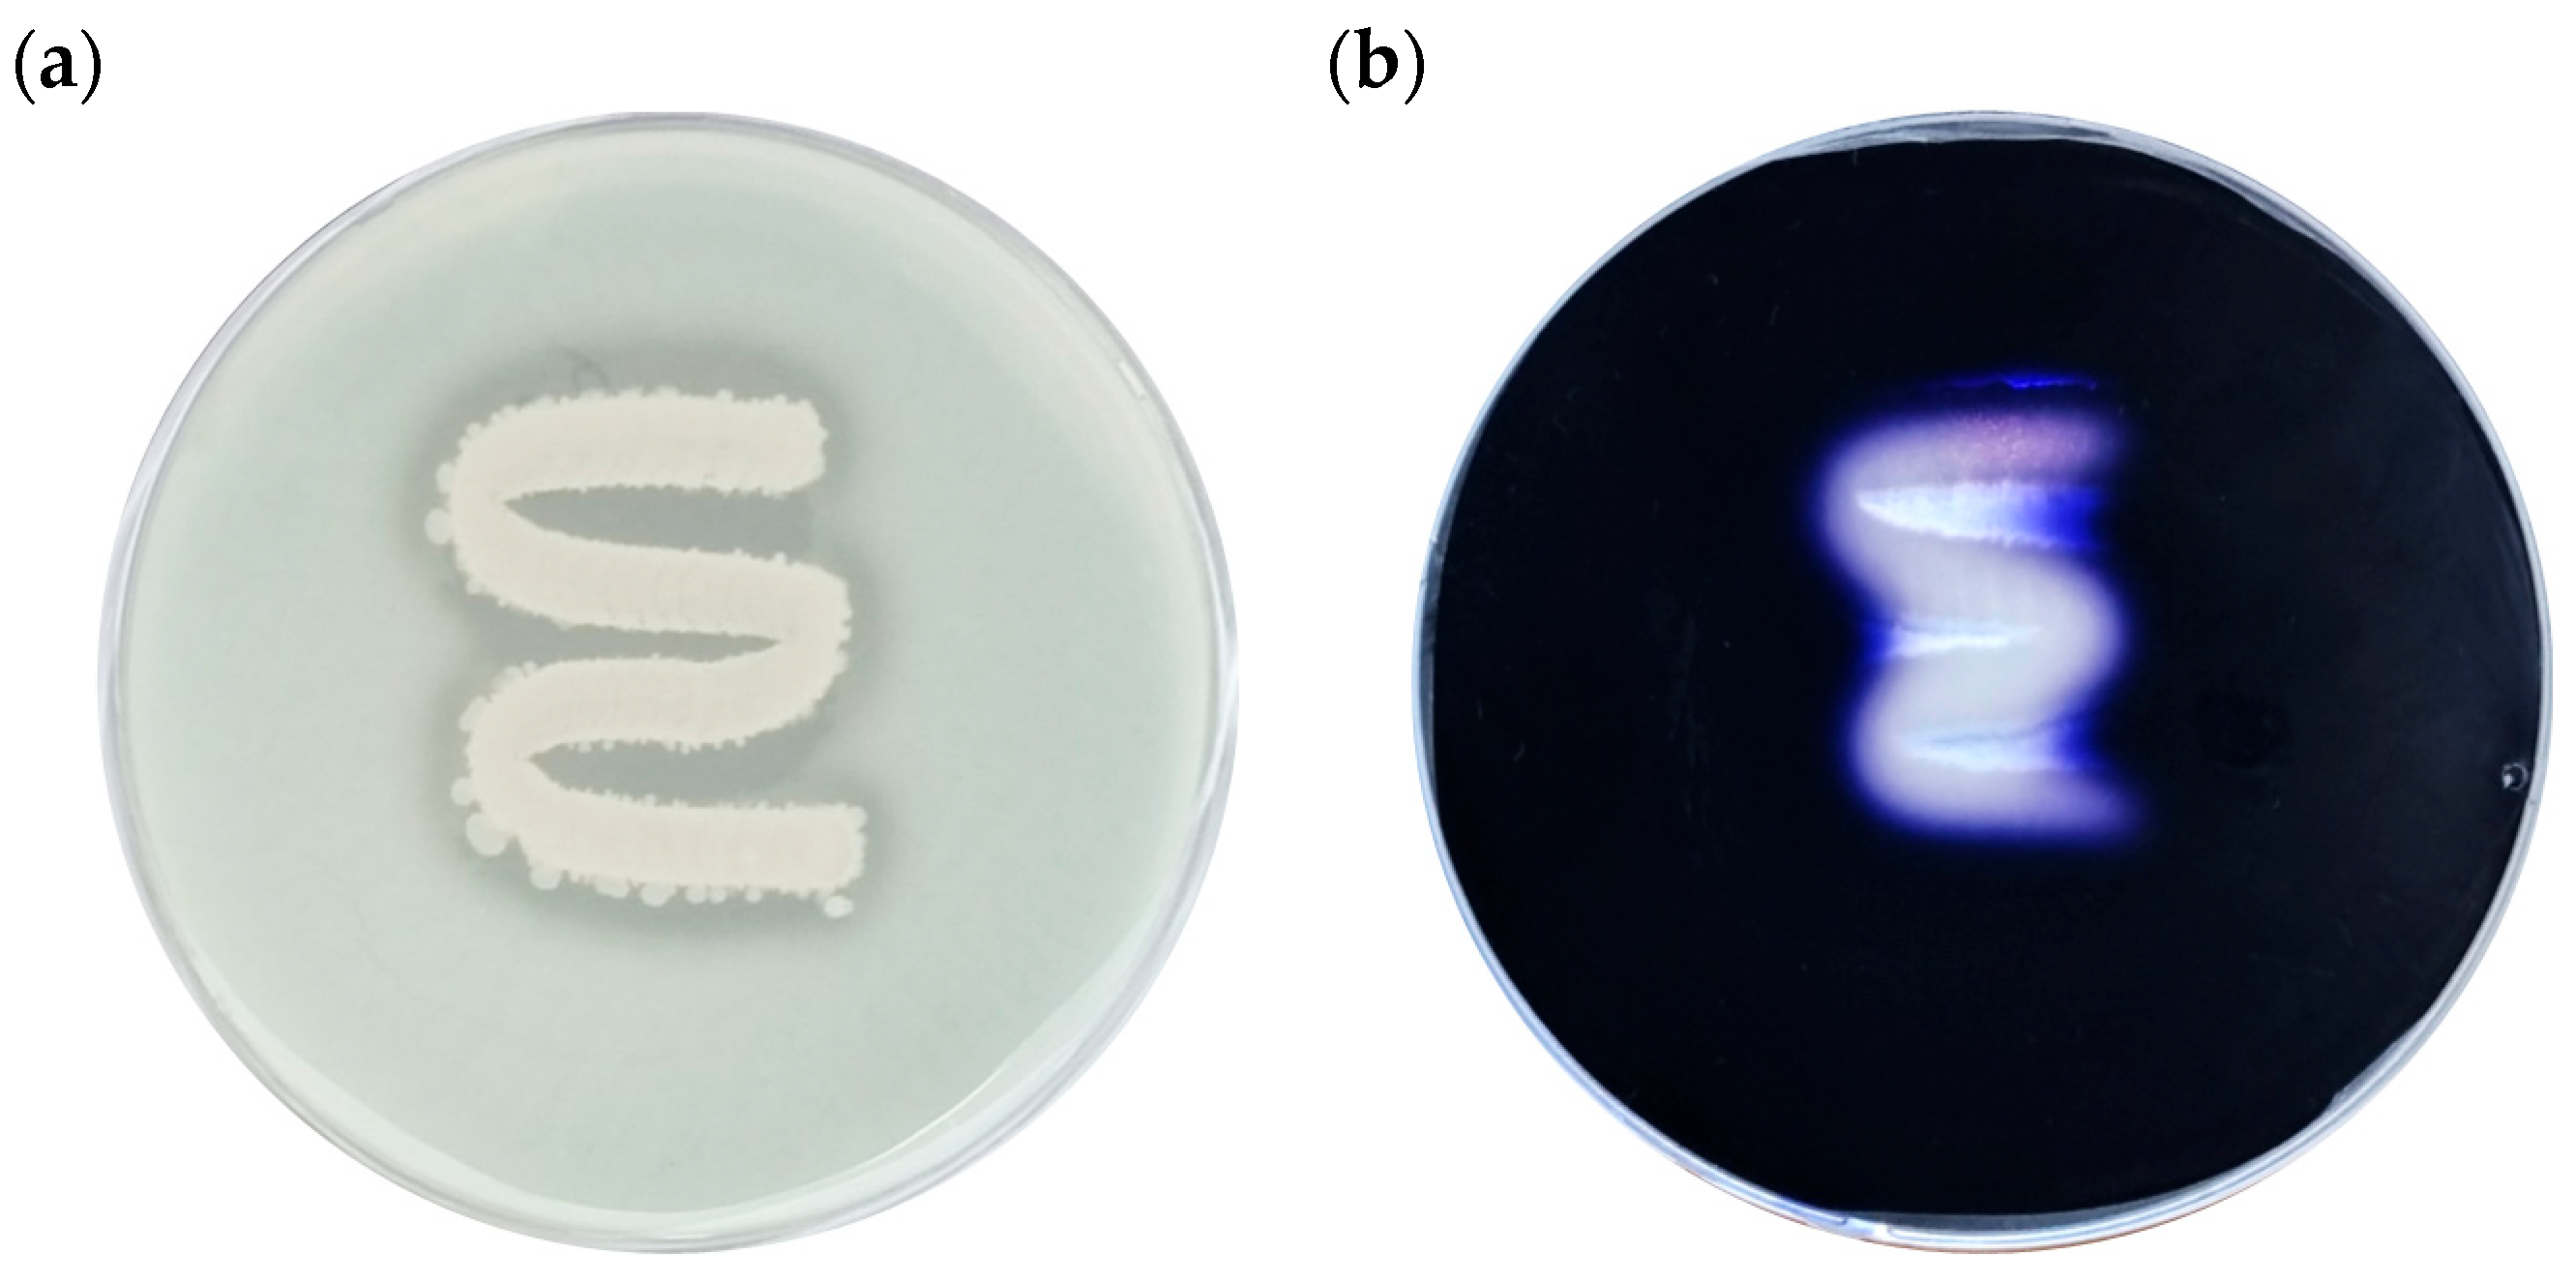
Foods 14 03592 g009 Foods 14 03592 g009

Isolation of Biofilm-Forming Bacteria from Food Processing Equipment Surfaces and the Biofilm-Degrading Activity of Bacillus licheniformis YJE5
Abstract
1. Introduction
2. Materials and Methods
2.1. Sample Collection from Food Processing Facility
2.2. Isolation and Identification
2.3. Hemolysis Assay on Blood Agar
2.4. Preparation of Intracellular Substances from B. licheniformis YJE5
2.5. BCA Protein Assay
2.6. Biofilm Formation Inhibitory Activity
2.7. Biofilm Degradation Activity
2.8. Observation of Biofilm Degradation by Light Microscopy
2.9. Evaluation of Biofilm Formation in Response to NaCl and Dextrose Concentration
2.10. Confocal Laser Scanning Microscopy (CLSM) Imaging of the Biofilm
2.11. Evaluation of α-Amylase and Protease Activities in B. licheniformis YJE5
2.12. Enzyme Activity Determination Using the API ZYM Kit
2.13. Cell Viability Assay
2.14. Genome Sequencing and Assembly
2.15. Prediction of Antimicrobial Resistance Gene and Potential Virulence Factors
2.16. Gene Prediction and Functional Annotation
2.17. Statistical Analysis
3. Results
3.1. Isolation and Identification of Bacteria from Food Processing Equipment Surfaces and Environments
3.2. Hemolytic Activity
3.3. Inhibition of Biofilm Formation by B. licheniformis YJE5 Intracellular Substances (ICS)
3.4. Biofilm-Degrading Activity of ICS from B. licheniformis YJE5
3.5. Observation of Biofilm Degradation Following Treatment with ICS from B. licheniformis YJE5
3.6. Evaluation of Biofilm Formation at Various Concentrations of NaCl and Dextrose
3.7. CLSM Analysis of Biofilm-Degrading Activity of ICS from B. licheniformis YJE5
3.8. Enzymatic Activities of B. licheniformis YJE5
3.9. Enzymatic Activity Profile of B. licheniformis YJE5 Determined Using the API ZYM Kit
3.10. Determination of Cell Viability of ICS from B. licheniformis YJE5
3.11. Whole-Genome Sequencing Analysis of B. licheniformis YJE5
4. Discussion
5. Conclusions
Author Contributions
Funding
Institutional Review Board Statement
Informed Consent Statement
Data Availability Statement
Conflicts of Interest
References
- Schmidt, R. Food equipment hygienic design: An important element of a food safety program. Food Saf. Mag. 2012, 18, 14–17. Available online: https://www.foodsafetymagazine.com/magazine-archive1/december-2012january-2013/food-equipment-hygienic-design-an-important-element-of-a-food-safety-program (accessed on 27 January 2021).
- Havelaar, A.H.; Kirk, M.D.; Torgerson, P.R.; Gibb, H.J.; Hald, T.; Lake, R.J.; Praet, N.; Bellinger, D.C.; de Silva, N.R.; Gargouri, N.; et al. World Health Organization global estimates and regional comparisons of the burden of foodborne disease in 2010. PLoS Med. 2015, 12, e1001923. [Google Scholar] [CrossRef] [PubMed]
- Coughlan, L.M.; Cotter, P.D.; Hill, C.; Alvarez-Ordóñez, A. New weapons to fight old enemies: Novel strategies for the (bio)control of bacterial biofilms in the food industry. Front. Microbiol. 2016, 7, 1641. [Google Scholar] [CrossRef] [PubMed]
- Winkelströter, L.K.; Gomes, B.C.; Thomaz, M.R.S.; Souza, V.M.; De Martinis, E.C.P. Unraveling microbial biofilms of importance for food microbiology. Microb. Ecol. 2014, 68, 35–46. [Google Scholar] [CrossRef]
- Laughman, C. How food processors can fight cross-contamination. Food Eng. 2018. Available online: https://www.foodengineeringmag.com/articles/97333-how-food-processorscan-fight-cross-contamination (accessed on 12 July 2022).
- Aviat, F.; Le Bayon, I.; Federighi, M.; Montibus, M. Comparative study of microbiological transfer from four materials used in direct contact with apples. Int. J. Food Microbiol. 2020, 333, 108780. [Google Scholar] [CrossRef] [PubMed]
- Centers for Disease Control and Prevention. How Food Gets Contaminated—The Food Production Chain; Centers for Disease Control and Prevention: Atlanta, GA, USA, 2017. [Google Scholar]
- Axelsson, L.; Holck, A.; Rud, I.; Samah, D.; Tierce, P.; Favre, M.; Kure, C.F. Cleaning of conveyor belt materials using ultrasound in a thin layer of water. J. Food Prot. 2013, 76, 1401–1407. [Google Scholar] [CrossRef]
- Kusumaningrum, H.D.; Riboldi, G.; Hazeleger, W.C.; Beumer, R.R. Survival of foodborne pathogens on stainless steel surfaces and cross-contamination to foods. Int. J. Food Microbiol. 2003, 85, 227–236. [Google Scholar] [CrossRef]
- Ryu, J.H.; Beuchat, L.R. Biofilm formation and sporulation by Bacillus cereus on a stainless steel surface and subsequent resistance of vegetative cells and spores to sanitizers. J. Food Prot. 2005, 68, 2614–2622. [Google Scholar] [CrossRef]
- Lehto, M.; Kuisma, R.; Määttä, J.; Kymäläinen, H.R.; Mäki, M. Hygienic level and surface contamination in fresh-cut vegetable production plants. Food Control 2011, 22, 469–475. [Google Scholar] [CrossRef]
- Flemming, H.C.; Wingender, J.; Szewzyk, U.; Steinberg, P.; Rice, S.A.; Kjelleberg, S. Biofilms: An emergent form of bacterial life. Nat. Rev. Microbiol. 2016, 14, 563–575. [Google Scholar] [CrossRef]
- Decho, A.W.; Gutierrez, T. Microbial extracellular polymeric substances (EPSs) in ocean systems. Front. Microbiol. 2017, 8, 922. [Google Scholar] [CrossRef] [PubMed]
- Seviour, T.; Derlon, N.; Dueholm, M.S.; Flemming, H.C.; Girbal-Neuhauser, E.; Horn, H.; Kjelleberg, S.; van Loosdrecht, M.C.; Lotti, T.; Malpei, M.F.; et al. Extracellular polymeric substances of biofilms: Suffering from an identity crisis. Water Res. 2019, 151, 1–7. [Google Scholar] [CrossRef] [PubMed]
- Zhao, X.; Zhao, F.; Wang, J.; Zhong, N. Biofilm formation and control strategies of foodborne pathogens: Food safety perspectives. RSC Adv. 2017, 7, 36670–36683. [Google Scholar] [CrossRef]
- Batoni, G.; Maisetta, G.; Esin, S. Antimicrobial peptides and their interaction with biofilms of medically relevant bacteria. Biochim. Biophys. Acta Biomembr. 2016, 1858, 1044–1060. [Google Scholar] [CrossRef]
- Tewari, A.; Jain, B.; Dhamannapatil, P.S.; Saxena, M.K. Biofilm resistance to antimicrobial agents and novel approaches to combat biofilm mediated resistance. EC Microbiol. 2018, 14, 71–77. [Google Scholar]
- Yin, W.; Wang, Y.; Liu, L.; He, J. Biofilms: The microbial “protective clothing” in extreme environments. Int. J. Mol. Sci. 2019, 20, 3423. [Google Scholar] [CrossRef]
- Alexander, M. Introduction to soil microbiology. Soil Sci. 1978, 125, 331. [Google Scholar] [CrossRef]
- Dong, Z.; Chen, X.; Cai, K.; Chen, Z.; Wang, H.; Jin, P.; Liu, X.; Permaul, K.; Singh, S.; Wang, Z. Exploring the metabolomic responses of Bacillus licheniformis to temperature stress by gas chromatography/mass spectrometry. J. Microbiol. Biotechnol. 2018, 28, 473–481. [Google Scholar] [CrossRef]
- Qi, N.; Zhan, X.; Milmine, J.; Sahar, M.; Chang, K.H.; Li, J. Isolation and characterization of a novel hydrolase-producing probiotic Bacillus licheniformis and its application in soybean meal fermentation. Front. Nutr. 2023, 10, 1123422. [Google Scholar] [CrossRef]
- Argyri, A.A.; Zoumpopoulou, G.; Karatzas, K.A.; Tsakalidou, E.; Nychas, G.J.; Panagou, E.Z.; Tassou, C.C. Selection of potential probiotic lactic acid bacteria from fermented olives by in vitro tests. Food Microbiol. 2013, 33, 282–291. [Google Scholar] [CrossRef] [PubMed]
- Pawar, S.V.; Rathod, V.K. Ultrasound assisted process intensification of uricase and alkaline protease co-production in Bacillus licheniformis. Ultrason. Sonochem. 2018, 45, 173–179. [Google Scholar] [CrossRef]
- Sun, Y.; Jiang, W.; Zhang, M.; Zhang, L.; Shen, Y.; Huang, S.; Li, M.; Qiu, W.; Pan, Y.; Zhou, L.; et al. The inhibitory effects of ficin on Streptococcus mutans biofilm formation. Biomed Res. Int. 2021, 2021, 6692328. [Google Scholar] [CrossRef]
- Jaffar, N.; Ishikawa, Y.; Mizuno, K.; Okinaga, T.; Maeda, T. Mature biofilm degradation by potential probiotics: Aggregatibacter actinomycetemcomitans versus Lactobacillus spp. PLoS ONE 2016, 11, e0159466. [Google Scholar] [CrossRef]
- Bakkiyaraj, D.; Sritharadol, R.; Padmavathi, A.R.; Nakpheng, T.; Srichana, T. Anti-biofilm properties of a mupirocin spray formulation against Escherichia coli wound infections. Biofouling 2017, 33, 591–600. [Google Scholar] [CrossRef]
- Vilarrasa, J.; Delgado, L.M.; Galofré, M.; Àlvarez, G.; Violant, D.; Manero, J.M.; Blanc, V.; Gil, F.J.; Nart, J. In vitro evaluation of a multispecies oral biofilm over antibacterial coated titanium surfaces. J. Mater. Sci. Mater. Med. 2018, 29, 164. [Google Scholar] [CrossRef]
- Zhang, J.; Wu, H.; Wang, D.; Wang, L.; Cui, Y.; Zhang, C.; Zhao, K.; Ma, L. Intracellular glycosyl hydrolase PslG shapes bacterial cell fate and biofilm development of Pseudomonas aeruginosa. eLife 2022, 11, e72778. [Google Scholar]
- Masi, C.; Gemechu, G.; Tafesse, M. Isolation, screening, characterization, and identification of alkaline protease-producing bacteria from leather industry effluent. Ann. Microbiol. 2021, 71, 24. [Google Scholar] [CrossRef]
- Yassin, S.N.; Jiru, T.M.; Indracanti, M. Screening and characterization of thermostable amylase-producing bacteria from soil samples and molecular detection of amylase gene. Int. J. Microbiol. 2021, 2021, 5592885. [Google Scholar] [CrossRef] [PubMed]
- Wick, R.R.; Judd, L.M.; Holt, K.E. Performance of neural network basecalling tools for Oxford Nanopore sequencing. Genome Biol. 2019, 20, 129. [Google Scholar] [CrossRef]
- Bonenfant, Q.; Noé, L.; Touzet, H. Porechop_ABI: Discovering unknown adapters in ONT sequencing reads. bioRxiv 2022, 2007, 499093. [Google Scholar] [CrossRef]
- Kolmogorov, M.; Yuan, J.; Lin, Y.; Pevzner, P.A. Assembly of long, error-prone reads using repeat graphs. Nat. Biotechnol. 2019, 37, 540–546. [Google Scholar] [CrossRef]
- Manni, M.; Berkeley, M.R.; Seppey, M.; Simão, F.A.; Zdobnov, E.M. BUSCO update: Novel and streamlined workflows with deeper phylogenetic coverage. Mol. Biol. Evol. 2021, 38, 4647–4654. [Google Scholar] [CrossRef]
- Bortolaia, V.; Kaas, R.S.; Ruppe, E.; Roberts, M.C.; Schwarz, S.; Cattoir, V.; Philippon, A.; Allesoe, R.L.; Rebelo, A.R.; Florensa, A.F.; et al. ResFinder 4.0 for predictions of phenotypes from genotypes. J. Antimicrob. Chemother. 2020, 75, 3491–3500. [Google Scholar] [CrossRef]
- Feldgarden, M.; Brover, V.; Gonzalez-Escalona, N.; Frye, J.G.; Haendiges, J.; Haft, D.H.; Hoffmann, M.; Pettengill, J.B.; Prasad, A.B.; Tillman, G.E.; et al. AMRFinderPlus and the Reference Gene Catalog facilitate genomic links among antimicrobial resistance, stress response, and virulence. Sci. Rep. 2021, 11, 12728. [Google Scholar] [CrossRef] [PubMed]
- Chen, L.; Yang, J.; Yu, J.; Yao, Z.; Sun, L.; Shen, Y.; Jin, Q. VFDB: A reference database for bacterial virulence factors. Nucleic Acids Res. 2005, 33, D325–D328. [Google Scholar] [CrossRef] [PubMed]
- Buchfink, B.; Reuter, K.; Drost, H.G. Sensitive protein alignments at tree-of-life scale using DIAMOND. Nat. Methods 2021, 18, 366–368. [Google Scholar] [CrossRef]
- Umanets, A.; Surono, I.S.; Venema, K. I am better than I look: Genome based safety assessment of Lactiplantibacillus plantarum IS-10506. BMC Genom. 2023, 24, 518. [Google Scholar] [CrossRef]
- Seemann, T. Prokka: Rapid prokaryotic genome annotation. Bioinformatics 2014, 30, 2068–2069. [Google Scholar] [CrossRef] [PubMed]
- Grant, J.R.; Enns, E.; Marinier, E.; Mandal, A.; Herman, E.K.; Chen, C.Y.; Graham, M.; Van Domselaar, G.; Stothard, P. Proksee: In-depth characterization and visualization of bacterial genomes. Nucleic Acids Res. 2023, 51, W484–W492. [Google Scholar] [CrossRef]
- Lad, V.; Panchal, D.; Pithawala, M.; Dwivedi, M.K.; Amaresan, N. Determination of hemolytic activity. In Biosafety Assessment of Probiotic Potential; Springer: New York, NY, USA, 2022; pp. 43–46. [Google Scholar]
- Dai, H.; Chen, A.; Wang, Y.; Lu, B.; Wang, Y.; Chen, J.; Huang, Y.; Li, Z.; Fang, Y.; Xiao, T.; et al. Proteus faecis sp. nov., and Proteus cibi sp. nov., two new species isolated from food and clinical samples in China. Int. J. Syst. Evol. Microbiol. 2019, 69, 852–858. [Google Scholar] [CrossRef]
- Rode, T.M.; Langsrud, S.; Holck, A.; Møretrø, T. Different patterns of biofilm formation in Staphylococcus aureus under food-related stress conditions. Int. J. Food Microbiol. 2007, 116, 372–383. [Google Scholar] [CrossRef] [PubMed]
- Kwon, M.; Hussain, M.S.; Oh, D.H. Biofilm formation of Bacillus cereus under food-processing-related conditions. Food Sci. Biotechnol. 2017, 26, 1103–1111. [Google Scholar] [CrossRef] [PubMed]
- de Souza, P.M.; de Oliveira Magalhães, P. Application of microbial α-amylase in industry—A review. Braz. J. Microbiol. 2010, 41, 850–861. [Google Scholar] [CrossRef]
- Sánchez-Milla, M.; Hernández-Corroto, E.; Sánchez-Nieves, J.; Gómez, R.; Marina, M.L.; García, M.C.; de la Mata, F.J. Immobilization of Alcalase on silica supports modified with carbosilane and PAMAM dendrimers. Int. J. Mol. Sci. 2022, 23, 16102. [Google Scholar] [CrossRef] [PubMed]
- UniProtKB–P00780 (SUBT_BACLI): Subtilisin Carlsberg (Alcalase) from Bacillus licheniformis. UniProtKB. Available online: https://www.uniprot.org/uniprotkb/P00780 (accessed on 23 September 2025).
- Chen, Y.; Zhang, R.; Zhang, W.; Xu, Y. Alanine aminopeptidase from Bacillus licheniformis E7 expressed in Bacillus subtilis efficiently hydrolyzes soy protein. LWT 2022, 165, 113642. [Google Scholar] [CrossRef]
- Wang, S.; Zhao, Y.; Breslawec, A.P.; Liang, T.; Deng, Z.; Kuperman, L.L.; Yu, Q. Strategy to combat biofilms: A focus on biofilm dispersal enzymes. NPJ Biofilms Microbiomes 2023, 9, 63. [Google Scholar] [CrossRef]
- Kivanç, M.; Yilmaz, M.; Karatas, S. Inactivation effect of probiotic biofilms on growth of Listeria monocytogenes. Kafkas Univ. Vet. Fak. Derg. 2011, 17, 833–836. [Google Scholar]

| Enzymes | YJE5 | Enzymes | YJE5 |
|---|---|---|---|
| Control | - (1) | Acid phosphatase | + |
| Alkaline phosphatase | w (2) | Naphthol-AS-BI-phosphohydrolase | + |
| Esterase (C4) | + (3) | α-galactosidase | - |
| Esterase Lipase (C8) | w | β-glucuronidase | - |
| Lipase (C14) | - | β-glucosidase | - |
| Leucine arylamidase | w | α-glucosidase | - |
| Valine arylamidase | w | β-glucosidase | - |
| Crystine arylamidase | + | N-acetyl-β-glucosaminidase | - |
| Trypsin | + | α-mannosidase | - |
| α-chymotrypsin | + | α-fucosidase | - |
| Features | |
|---|---|
| Genome size (bp) | 4,328,805 |
| GC content (%) | 45.95 |
| Coding sequence (CDS) | 4391 |
| rRNA | 24 |
| tRNA | 81 |
Disclaimer/Publisher’s Note: The statements, opinions and data contained in all publications are solely those of the individual author(s) and contributor(s) and not of MDPI and/or the editor(s). MDPI and/or the editor(s) disclaim responsibility for any injury to people or property resulting from any ideas, methods, instructions or products referred to in the content. |
© 2025 by the authors. Licensee MDPI, Basel, Switzerland. This article is an open access article distributed under the terms and conditions of the Creative Commons Attribution (CC BY) license (https://creativecommons.org/licenses/by/4.0/).
Share and Cite
Yu, D.; Lee, J.-E.; Rhee, M.-S.; Shim, S.-M.; Om, A.-S.; Yu, H.; Kook, M. Isolation of Biofilm-Forming Bacteria from Food Processing Equipment Surfaces and the Biofilm-Degrading Activity of Bacillus licheniformis YJE5. Foods 2025, 14, 3592. https://doi.org/10.3390/foods14213592
Yu D, Lee J-E, Rhee M-S, Shim S-M, Om A-S, Yu H, Kook M. Isolation of Biofilm-Forming Bacteria from Food Processing Equipment Surfaces and the Biofilm-Degrading Activity of Bacillus licheniformis YJE5. Foods. 2025; 14(21):3592. https://doi.org/10.3390/foods14213592
Chicago/Turabian StyleYu, Duna, Jeong-Eun Lee, Min-Suk Rhee, Soon-Mi Shim, Ae-Son Om, Hary Yu, and Moochang Kook. 2025. "Isolation of Biofilm-Forming Bacteria from Food Processing Equipment Surfaces and the Biofilm-Degrading Activity of Bacillus licheniformis YJE5" Foods 14, no. 21: 3592. https://doi.org/10.3390/foods14213592
APA StyleYu, D., Lee, J.-E., Rhee, M.-S., Shim, S.-M., Om, A.-S., Yu, H., & Kook, M. (2025). Isolation of Biofilm-Forming Bacteria from Food Processing Equipment Surfaces and the Biofilm-Degrading Activity of Bacillus licheniformis YJE5. Foods, 14(21), 3592. https://doi.org/10.3390/foods14213592

